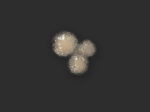
SB11 Insektenstich

SB11 Insektenstich
€ 19,93 inkl. MwSt.
Auf Anfrage sind zusätzlich alle Verarbeitungsmaterialien erhältlich.
Größe: 2,5 x 2 cm
Wunde: 1,5 x 1,2 cm
- Handgefertigtes Qualitätsprodukt
- Kühl und trocken lagern
- Verarbeitungshinweise im Paket beiliegend
Dieses Produkt ist als Bondo-Transfer erhältlich.
Bondo-Transfer
Optimal geeignet für den stressigen Set-Alltag: einfach und schnell zu
kleben und auch an langen Drehtagen zuverlässig auf der Haut haltbar.
Inhaltsstoffe: Prosaide, Farbpigment
Da der Herstellungsprozess unserer Prosthetics mehrere Tage in Anspruch
nimmt, bitten wir darum, besonders bei größeren Bestellungen ausreichend
Vorlaufzeit vor eurem Drehtermin einzuplanen.
Bitte beachte, dass unsere Prosthetics und Tattoos extra für Dich und
Deine Zwecke angefertigt werden. Aus diesem Grund, und auch aus
hygienischen Gründen, ist ein Umtausch, eine Rücksendung oder
Rückerstattung ausgeschlossen. Eine Stornierung nach Versand der Waren ist
ebenfalls nicht möglich. Vielen Dank für Dein Verständnis.
Du musst angemeldet sein, um eine Rezension veröffentlichen zu können.
Hier kommen in Kürze alle Versandinformationen.

Rezensionen
Es gibt noch keine Rezensionen.